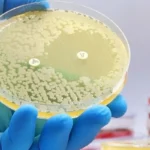
bacteria in tap water (2)

A Comprehensive Guide to Safe Sipping
- Published:
- Updated: November 13, 2024
Summary
Safe water is crucial for human health and well-being. To ensure water safety:
- Test Your Water: Use water testing kits to check for contaminants and pollutants.
- Use a Water Filter: Invest in a water filter suitable for your needs and budget.
- Boil Your Water: Boiling water for at least one minute kills pathogens.
- Drink from Safe Sources: Choose public water supplies or regularly tested private wells.
The water we have is not just vital to human health and wellbeing but integral to our lives. With access to safe, uncontaminated water, not only do waterborne diseases remain in check, but so do hygiene, sanitation, and quality of life. Yet millions of people still don’t have access to this essential ingredient, making them even poorer and limiting social and economic growth. Therefore, learning the value of clean water and working to make sure that all can have access to it is a global priority that must be resolved now.
What is Safe Water?
Safe water is water that doesn’t have pollutants and impurities in it that could damage our health. Safe water must be chemical-, pathogen- and other harmful substance-free, and must be human-safe. It must also be clean of tastes, odours and colours that would make it objectionable to drink.
It can be quite damaging to our health if the water we consume is not of a good quality, and we should always ensure that the water we consume is pure and has no contaminants in it. Consuming a contaminated water causes many diseases such as stomach illnesses, infection, and many other grave conditions. To make sure that the water you are drinking is safe, learn what safe water is and what contaminants and pollutants to be concerned with.
How to Ensure that Your Water is Safe
Some things you can do to make sure the water you consume is safe are:
Don’t Drink Tap Water: Make sure you test your tap water to see if it isn’t contaminated and contaminated. There are many water testing kits you can use to know whether your water is clean or not. These kits are simple to use and can show you results in a matter of minutes.
Install a Water Filter: A water filter will get rid of contaminants and contaminants in your water so that it is safe to drink. There are many different kinds of water filters, and you need to find the right type of filter for you. Water filters aren’t inexpensive so you need to get one you can afford.
Boil Water: Boiling water kills pathogens and your water is safe to drink. Boiling water for at least one minute kills most pathogens so it’s a fast and easy way to make sure that your water is safe to drink. It’s especially handy if you live in a part of the world where water quality is not ideal or are on the road and don’t have a water filter nearby.
Drink from a Safe Source: Drink from a safe source (for example, a public water source or a private well that has been tested on a regular basis). Drinking from a clean water source can help make sure that your water is free of contaminants and pollutants. Keep track of any water quality advisories around you and act accordingly.

What is the Impact of Poor Water Quality on Health?
Drinking contaminated water can have serious impacts on our health, and it is important to be aware of the risks associated with drinking poor quality water. Contaminants and pollutants in water can cause a range of health problems, including:
- Gastrointestinal Illnesses: Drinking contaminated water can lead to gastrointestinal illnesses, such as diarrhea, vomiting, and abdominal cramps. These illnesses can be caused by pathogens in the water, such as bacteria and viruses.
- Infections: Contaminated water can also lead to infections, such as urinary tract infections, skin infections, and eye infections. These infections can be caused by pathogens in the water, as well as by pollutants and chemicals in the water.
- Chronic Health Conditions: Chronic health conditions, such as cancer and liver disease, can also be caused by exposure to contaminants and pollutants in water. These contaminants and pollutants can accumulate in our bodies over time, leading to long-term health problems.
The Importance of Water Testing for Safe Drinking Water
Water testing is a crucial step in ensuring that the water we drink is safe and free from contaminants and pollutants. Regular water testing can help to detect any problems early on, allowing us to take appropriate action to correct the issue. There are many different types of water testing available, including testing for bacteria, viruses, chemicals, and other contaminants.
It is important to have a good understanding of the different types of water testing available, and to choose the right type of testing for your needs. For example, if you are concerned about bacteria in your water supply, you may choose to have your water tested for coliform bacteria. On the other hand, if you are concerned about chemicals in your water, you may choose to have your water tested for specific chemicals, such as lead or pesticides.
The Benefits of Drinking Filtered Water
Drinking filtered water has many benefits for our health and overall well-being. Filtered water is free from contaminants and pollutants, making it safer to drink. In addition, drinking filtered water can also have other benefits, including:
- Improved Hydration: Filtered water is free from contaminants and pollutants that can make it difficult for our bodies to absorb and retain water. This means that filtered water can help to improve our overall hydration, making it easier for our bodies to function properly.
- Better Taste: Filtered water is free from unpleasant tastes, odors, and colors, making it more enjoyable to drink. This can help to encourage people to drink more water, improving their overall hydration and health.
- Increased Energy: Filtered water is free from contaminants and pollutants that can make us feel tired and sluggish. Drinking filtered water can help to increase our energy levels, making it easier for us to perform at our best.
The Importance of Proper Water Storage and Treatment
Proper water storage and treatment is also essential for ensuring that the water we drink is safe and free from contaminants. It is important to store water in clean, airtight containers, and to treat water if necessary to remove any contaminants or pathogens. There are many different water treatment options available, including filtration, chlorination, and ultraviolet light treatment.
It is important to understand the different water treatment options available, and to choose the right option for your needs. For example, if you are concerned about bacteria in your water, you may choose to use a water filtration system that uses a combination of filtration and ultraviolet light treatment. On the other hand, if you are concerned about chemicals in your water, you may choose to use a water filtration system that uses activated carbon to remove chemicals from your water.
Community Initiatives to Improve Water Safety
Engaging in community initiatives can greatly enhance the quality and safety of drinking water:
- Local Water Testing Programs: Participate in or support local water testing programs to help identify and address water quality issues.
- Public Awareness Campaigns: Advocate for and participate in public awareness campaigns to educate others about the importance of water safety.
- Volunteer with Environmental Groups: Join environmental groups that focus on protecting water sources from pollution and advocating for stronger water safety regulations.
- Support Water Infrastructure Projects: Advocate for and support local and national infrastructure projects aimed at improving water quality and access.
Conclusion: Ensuring Safe Drinking Water
Ensuring the safety of drinking water is essential for maintaining health and well-being. Understanding what constitutes safe water, regularly testing your water, and utilizing appropriate filtration and treatment methods are key steps in this process. By dispelling common myths and engaging in community initiatives, we can collectively work towards improving water quality for all. Safe water practices not only protect our health but also contribute to the overall sustainability and resilience of our communities
Share this on social media: